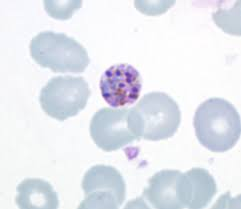
term image

Evolution and Diversity Test #1 Vocab
1/38
Name | Mastery | Learn | Test | Matching | Spaced | Call with Kai |
|---|
No analytics yet
Send a link to your students to track their progress
39 Terms
Evolution
The allele frequency shifts in a population over time
Natural Selection
Organisms become adapted to their circumstances which causes a change in allele frequency in a population
Population
Localized group of individuals capable of interbreeding and producing fertile offspring
Gene Pool
All the alleles for all loci in a population
Fixed
All the individuals in a population are homozygous for the same allele
Mutation
Provides new alleles/genes
Gene Flow
Movement of alleles in/out of a population
Genetic Drift
Evolution occurring due to chance events
Population Bottleneck
Size of a population drastically reduced so that only a few individuals are able to contribute genes to the next generation
Founder Effect
Isolated colonies founded by a small number of organisms
Directional Selection
Shifts traits in a specific direction
Stabilizing Selection
Favors individuals with average traits, acts against individuals that deviate too far from the mean
Disruptive Selection
Favors individuals at both extremes of a trait, and selects those without average traits
Balanced Polymorphism
Two or more phenotypes are maintained in a population because each is favored by a difference environmental force
Speciation
Origin of new species
Microevolution
Consists of changes in allele frequency in a population over time
Macroevolution
Refers to broad patterns of evolutionary change above the species level
Sister Taxa
Groups that share an immediate common ancestor
Rooted Tree
Includes a branch to represent the last common ancestor of all taxa in the tree
Basal Taxon
Diverges early, near the common ancestor of the group
Polytomy
Branch from which 2 or more groups emerge
Homology
Similarity due to shared ancestory
Analogy
Similarity due to convergent evolution
Convergent Evolution
Similar environmental pressures and natural selection produce similar adaptations
Clade
A group that includes an ancestral species and all its descendants
Monophyletic Clade
Includes a group of organisms with a single common ancestor and all its descendants
Paraphyletic Clade
A group of organisms with a common ancestor and some of its descendants

Trypanosoma
Plasmodium

Paramecium

Radiolarians

Foraminiferans

Red Algae

Spirogyra

Volvox

Diatoms

Chara

Dinogflagellates

Euglena